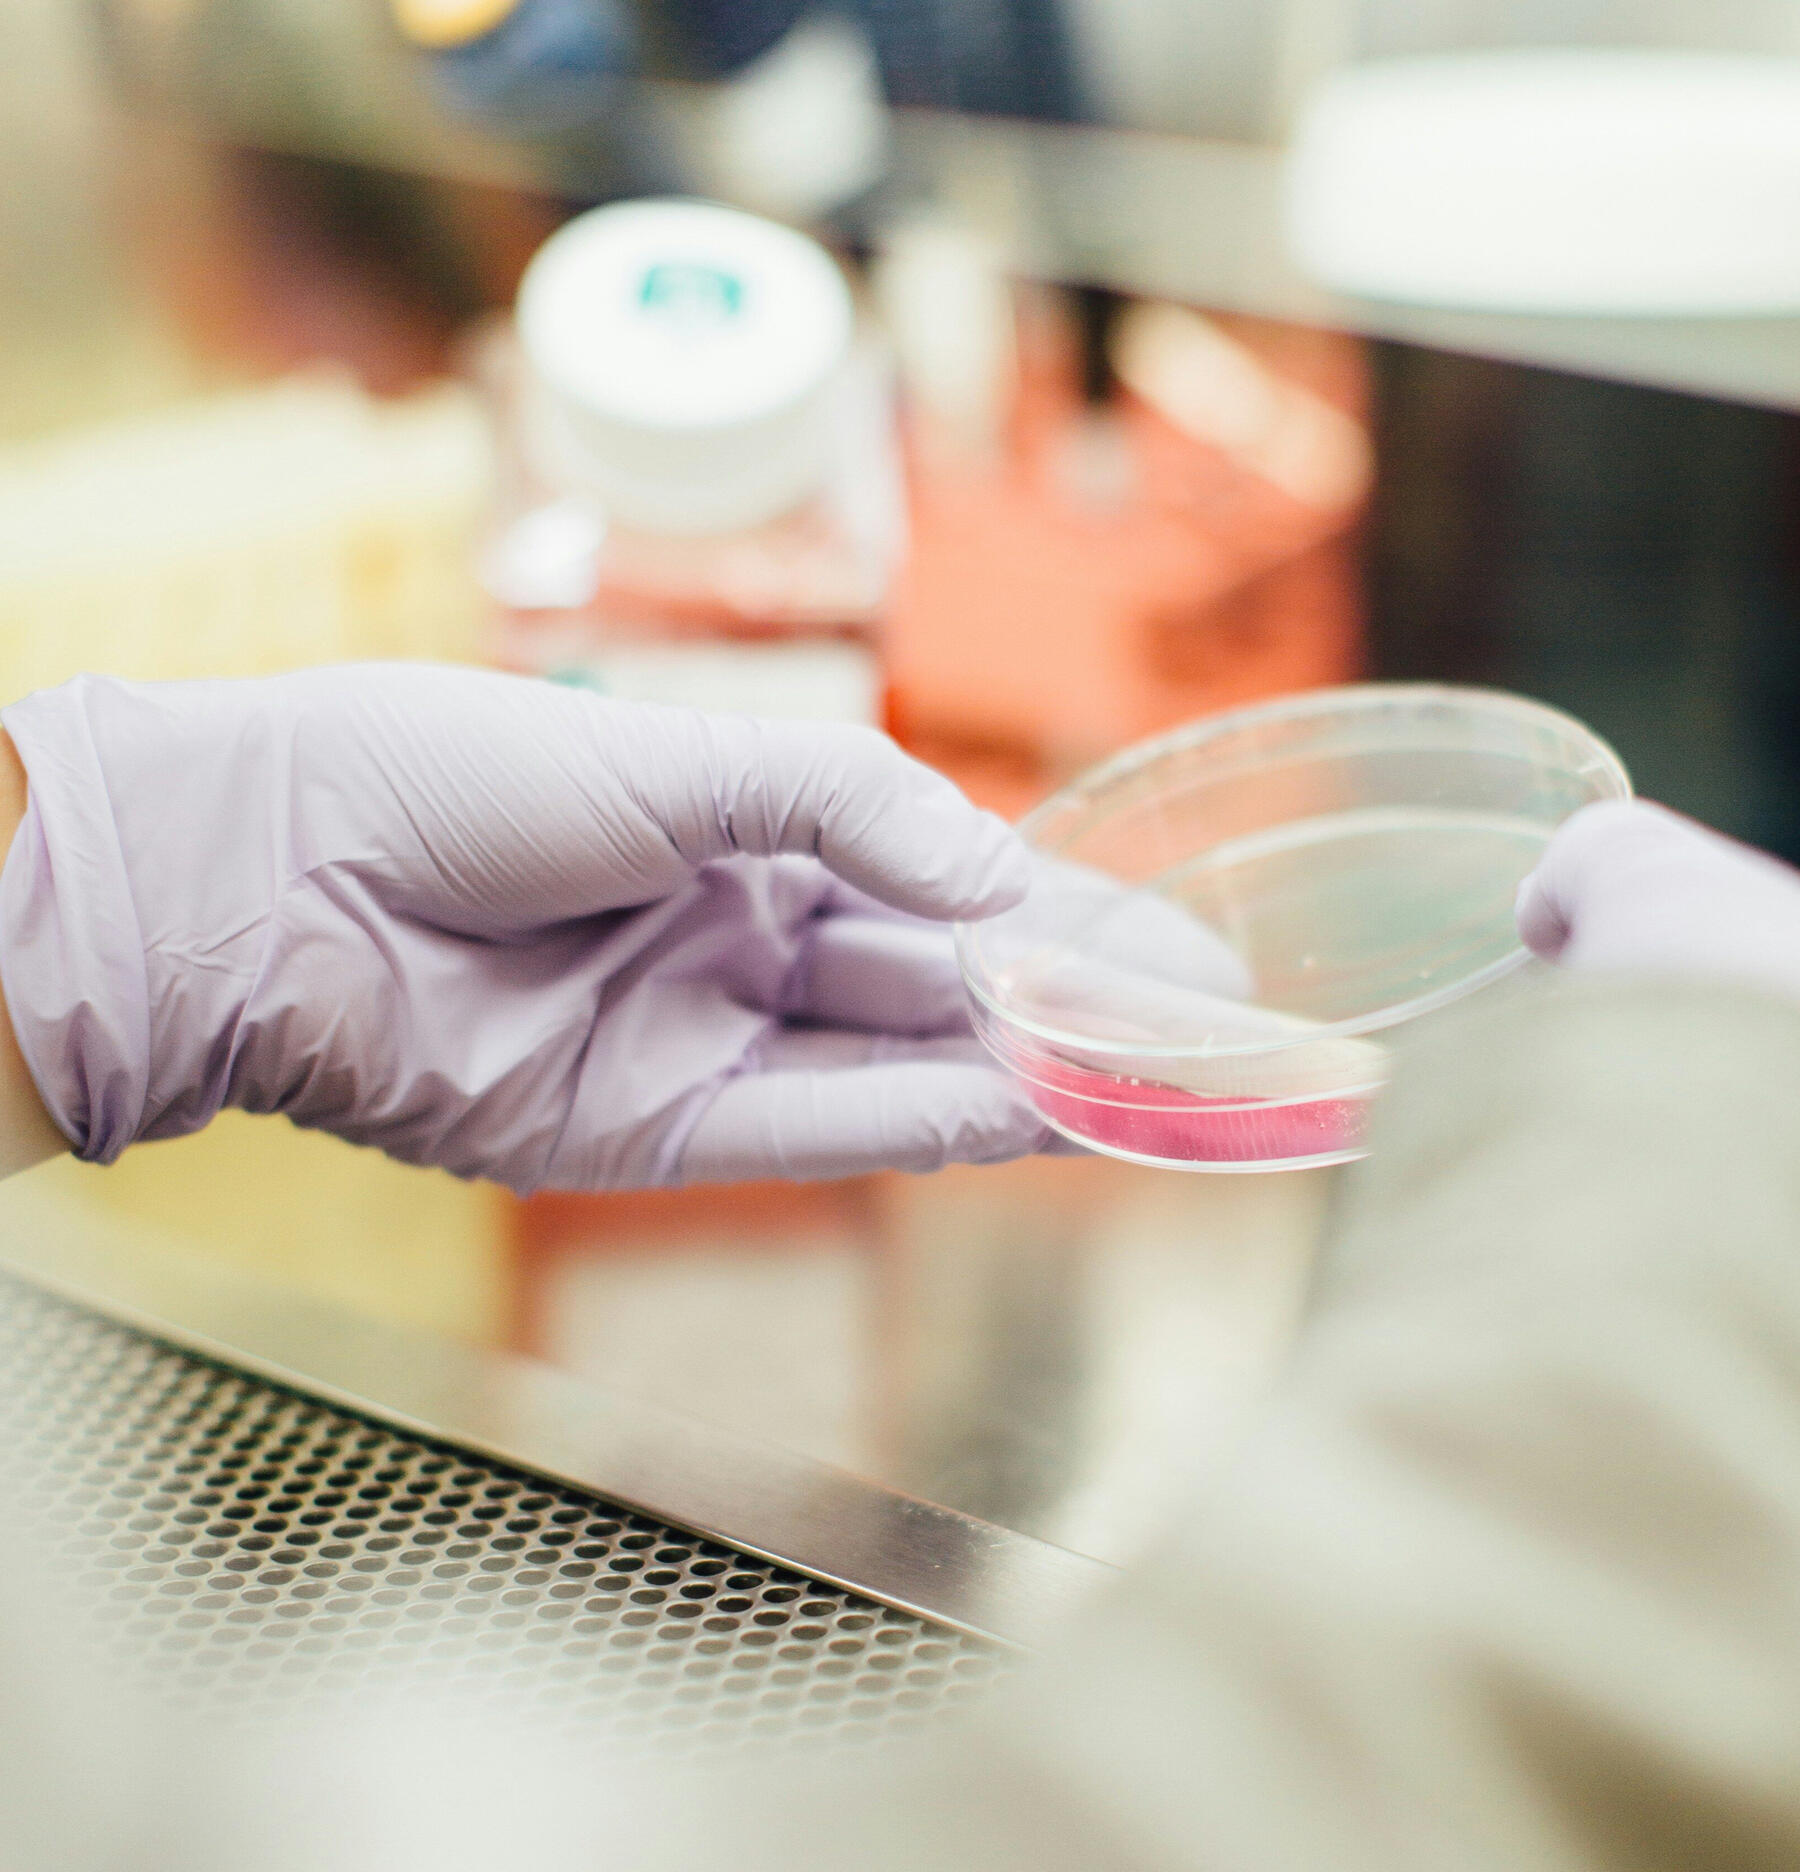

The Free IVF Clinic Review Site
Helping you find the right clinic with honest reviews from real families.
About us
With so many fertility clinics out there - how do you pick the one that's right for you?Success rates are measured differently from clinic to clinic, pricing is vague and important details are often absent. To top it off, IVF journeys are deeply personal, with many of us going through them privately, so you’re unlikely to know someone exactly in your position.Sarah’s Club is a grassroots movement, built by people who’ve experienced IVF firsthand. We’re crowdsourcing honest, in-depth reviews from patients around the world - covering real outcomes, costs and experiences across a wide range of fertility paths.By sharing our lived experiences, we can help others make more informed decisions, shifting the power dynamic in an industry that urgently needs greater transparency.Join Sarah’s Club today by submitting your clinic review. Thank you.
We're not live yet, but we're collecting reviews
Sarah’s Club is launching soon - enter your email below to join our mailing list and be kept in the know.
Are you a leading IVF clinic?
If you're committed to transparency and supporting IVF patients with clearer, more helpful information, we’d love to hear from you. Join us in building a more informed and empowered fertility community.